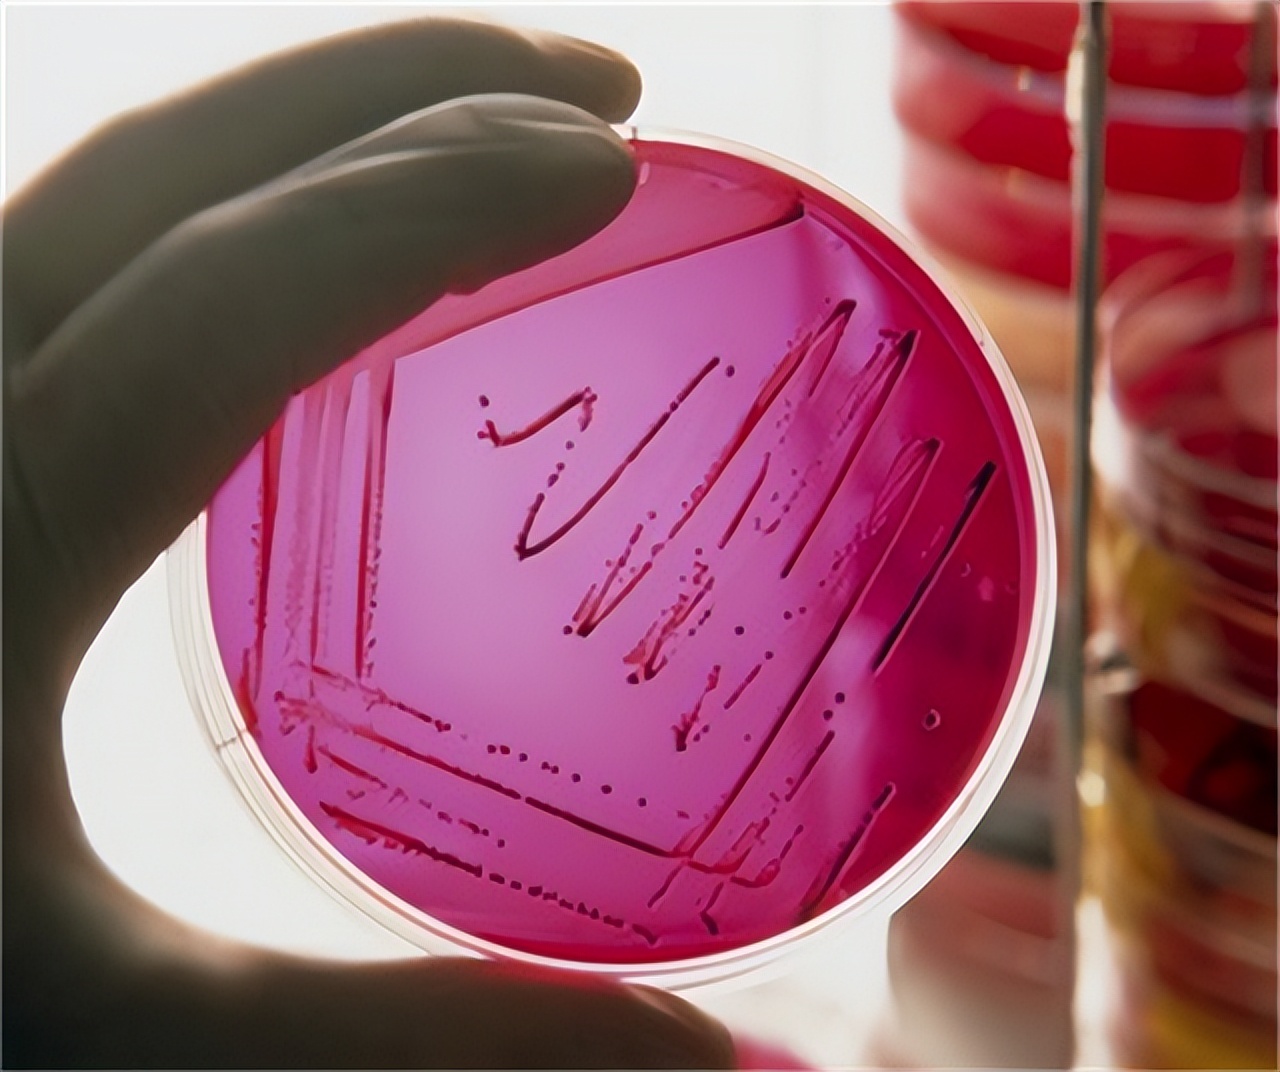
总感觉大便拉不干净，这是怎么回事？医生提醒：留意这3种病

门诊来了一位60岁的李先生,他满脸忧愁和困惑地对医生说:“我最近一个月上厕所时总会感到 排便不尽 ,有时还会出现肛门附近的坠胀感,而且蹲得越久就越严重。”

听了这话,医生若有所思,问道:“你以前消化功能如何,有过大便不成形的情况吗?”说完准备给李先生做进一步检查,“因为你年龄偏大,所以出现这类症状要十分警惕是不是有 肿瘤 的存在,所以我接下来要给你做一次 直肠指诊 ,放轻松”。
李先生听完同意了检查,接着他回复道:“我平素身体十分健康,但由于久坐时常有便秘,每次吃一些润肠通便的药物就好了。可是这次并没有任何好转,反而症状还在上厕所时越来越频繁和加重了,于是我就觉得不对劲了。”

医生边听着李先生的回复,边仔细地触诊李先生直肠内壁的黏膜。过了一会,他安抚李先生道:“刚给你做了检查,没有发现明显的异物,只是直肠黏膜有些脱垂。但为了保险起见,还是建议您做一个 肠镜 。”
一、为什么会出现排便不尽感?

正常人的大肠按照部位依次分为升结肠、横结肠、降结肠、乙状结肠和直肠,其中 直肠和肛门 附近组织有丰富的神经丛,因此 感觉十分敏锐 ,它们能够正确地分辨进入直肠内的物体是气体、液体还是固体,并且能够按照人的主观意愿来控制它们的排出。
人的粪便平时储存在乙状结肠内,而直肠内是不会有粪便的。当人上厕所时即为乙状结肠内的粪便下行至直肠下端, 刺激神经产生便意 ,便后直肠内又没有了内容物刺激,所以便意也就消失。

但如果 直肠内壁存在黏膜异物 ,或者像老李那样 直肠本身黏膜松弛脱垂 拥堵肠管,均会持续刺激直肠周围的神经、持续产生便意,这也正是排便后仍旧“意犹未尽”的原因。
排便不尽是一种主观感受,而会导致这种感觉的主要病因有三种,即直肠黏膜内脱垂、细菌性痢疾和直肠癌,接下来我们分节介绍这三类中各自的典型疾病或特征。
二、三种能引起“排便不尽感”的疾病
第①种:直肠黏膜内脱垂
直肠黏膜内脱垂是指直肠黏膜向肛门移位脱垂,但是还 没有脱出到肛门外 、肉眼看不到,仅仅通过检查才能发现,所以叫做“ 内脱垂 ”,而能看得见的痔疮就叫做“外脱垂”。

我们的肠壁有四层结构,由内向外分别是黏膜层、黏膜下层、肌层和浆膜层。其中最里面的黏膜层跟肠内容物直接接触,一旦出现黏膜脱垂就会造成肠腔相对狭窄,不易让粪便通过,于是也就产生了李先生的 排便不尽感 。
诊断方法主要两种,其中之一的 排粪造影检查 操作需要向患者肠道灌入钡剂,如果是女性还要往阴道内打入钡剂此时如果患者本就存在黏膜脱垂,再往直肠内注入内容物就会加重病情,因此这项检查虽然是 “金标准 ”,但许多医院并不会采用,此时就多采取第二个方法——根据医生 直肠指诊 的结果和经验来判断。如果指检时可以感受到患者直肠黏膜都松软地包绕在手指上,然后让患者模拟排便时会出现明显的黏膜挤压感,那么就可以做出初步诊断。

黏膜内脱垂 是一个动态的变化,当患者躺下时,直肠黏膜由于重力不再往肛门下坠产生压力,也就不会出现任何症状。只有在患者上厕所或者久站久坐后,才会有下移的黏膜压迫直肠内壁和肛门口产生便意和坠胀感。而这一类症状往往是肠镜或者B超无法发现的,这也解释了李先生为什么检查结果都正常但是症状却真实存在。
一旦出现直肠内脱垂,首先是要发现病因,然后想方法在日常生活中加以杜绝,防止病情进展;其次是可以在医生指导下采用 静脉增强剂联合中医辨证治疗 ,往往这样能取得较好治疗效果。
直肠内脱垂是最常见引起“大便不尽感”的疾病,这也正是开头病例中李先生的困扰,但除此以外,还有两种疾病需要注意。
第②种:细菌性痢疾

细菌性痢疾作为一种炎症,会持续刺激直肠导致其敏感性下降,从而分辨能力减弱,即使肠内没有内容物时也会产生便意,而引起这种感觉的直肠周围炎症最主要的是细菌性痢疾。
由于儿童和老年人抵抗力较弱,所以细菌性痢疾在这类人群中最常见,感染后的 潜伏期大概1~3天,最短可几小时发病,最长的也只有7天 ,不会出现李先生长达一个月的症状。正因为如此,医生在诊断李先生“大便不尽感”病因时首先就排除了细菌性痢疾。
作为细菌感染,它有特定的传播途径,即 粪-口途径传播 :病人多因食用受肥料污染的食物和水而感染。细菌性痢疾发病还具有明显的周期性,其高发期是每年夏季。因此在酷暑季节,许多旅客下河游泳前,要去了解水源附近是否有农、林等种植业地区。
细菌性痢疾的主要病变部位在降结肠,它常常会出现肠黏膜的溃疡坏死,造成 腹泻、腹痛、大便不尽和脓血便 ,如果病情严重会出现全身中毒症状如 发烧、乏力 ,其诊断则需要进行大便细菌培养,不能单纯依据典型的临床表现确诊。
临床上治疗多使用氟喹诺酮类药物 左氧氟沙星联合黄连素 。但近年来随着耐药菌株的不断出现,抗生素的使用受到诸多限制,控制传染源就显得十分重要。
直肠的炎症尽管症状复杂却尚易处理,而一旦出现恶性肿瘤,则往往会显著降低病人的生活质量。
第③种:直肠癌
直肠癌是消化系统最常见的恶性肿瘤之一。根据临床数据,早期直肠癌手术后5年生存率接近90%,但 晚期直肠癌生存率已降至14% ,因此早期诊断并及时手术是决定患者预后的关键。

直肠内生长了恶性肿瘤,便会形成占位,并且往往随着时间延长、肿瘤持续生长,使得原有的排便不尽感逐渐加重,还伴有 大便不成形、排便习惯改变 、甚至 鲜血或脓血样便 的症状。
一旦患者出现以上症状之一,特别是老年患者,就应该立即去医院做检查。目前公认的直肠癌最佳检查方式为 结肠镜 ,它能显示包括直肠在内的整个大肠,还能取部分黏膜组织进行活检,为直肠癌的发病作预警,前述医生建议李先生进行肠镜也正是出于此原因。

除此以外, 直肠指诊 这样一个简易的操作却能诊断出临床上绝大部分的直肠癌,有经验的医生通常会在病人柔软的肠壁上触摸到一个向腔内突出的 硬结 ,这就是疯狂生长的癌组织。
确诊了直肠癌后,只有采取 手术治疗 ,根据分类有传统开放手术、腹腔镜辅助手术和机器人手术等。但早期患者可以不切除肠管,而只做有癌组织相应部位的肠黏膜的局部剥离。
谈完了以上三种疾病的临床表现和治疗,那么生活中要如何预防这些疾病的发生呢?

三、科学预防,别让这些疾病找上门
预防重于治疗,在平时生活中我们必须养成良好的生活和饮食习惯、适当运动,还要按时体检并及时治疗相关疾病。
1)细菌性痢疾
由于痢疾杆菌是粪-口途径传播,所以在家里做饭时要将 蔬菜清洗干净 ,尤其是农村地区实行农家肥更需要注意。烹调时也需要加工彻底,少吃蔬菜沙拉和冷的剩饭剩菜。而在外就餐时 不要喝生的自来水 ,一定要烧开后再饮用。

2)直肠癌
直肠癌的发病因素与饮食不合理、不良生活习惯和遗传均有关,因此预防主要针对饮食结构的调整方面。对于一级亲属曾确诊过直肠癌的人群,在日常生活中不仅要多饮食新鲜瓜果蔬菜,也要避免烟熏、高盐类食物的摄入;高脂肪、高蛋白的食物必须适量食用。如果条件允许的话,推荐 每10年进行一次结肠镜检查 。
3)直肠黏膜内脱垂
因为直肠黏膜内脱垂是一个退行性疾病,但是不涉及病理改变,所以预防第一点是要纠正慢性便秘或能引起慢性腹压增高的因素,也不能做具有这样危险因素的运动,如举重深蹲等。平时可以多做 提肛运动 ,具体做法是规律地一提一松肛门,持续5~10分钟、每次做50次左右即可。

李先生虽然及时就医,但喜欢久坐、不运动,导致经常便秘最后发展为直肠黏膜内脱垂,因此他的治疗也必须从改善生活方式开始。但他又是幸运的,既遇到了经验丰富的医生,又没有患细菌性痢疾或者高发的直肠癌,说明饮食方面比较健康。
参考文献:
[1]王振宜.总感觉肛门坠胀、排便不尽咋回事[J].江苏卫生保健,2022(02):6-7.
[2]高璐.细菌性痢疾研究现状[J].职业与健康,2017,33(02):277-281.
[3]覃勇军.结直肠癌的发病因素及高危人群的预防对策[J].吉林医学,2021,42(06):1350-1352.